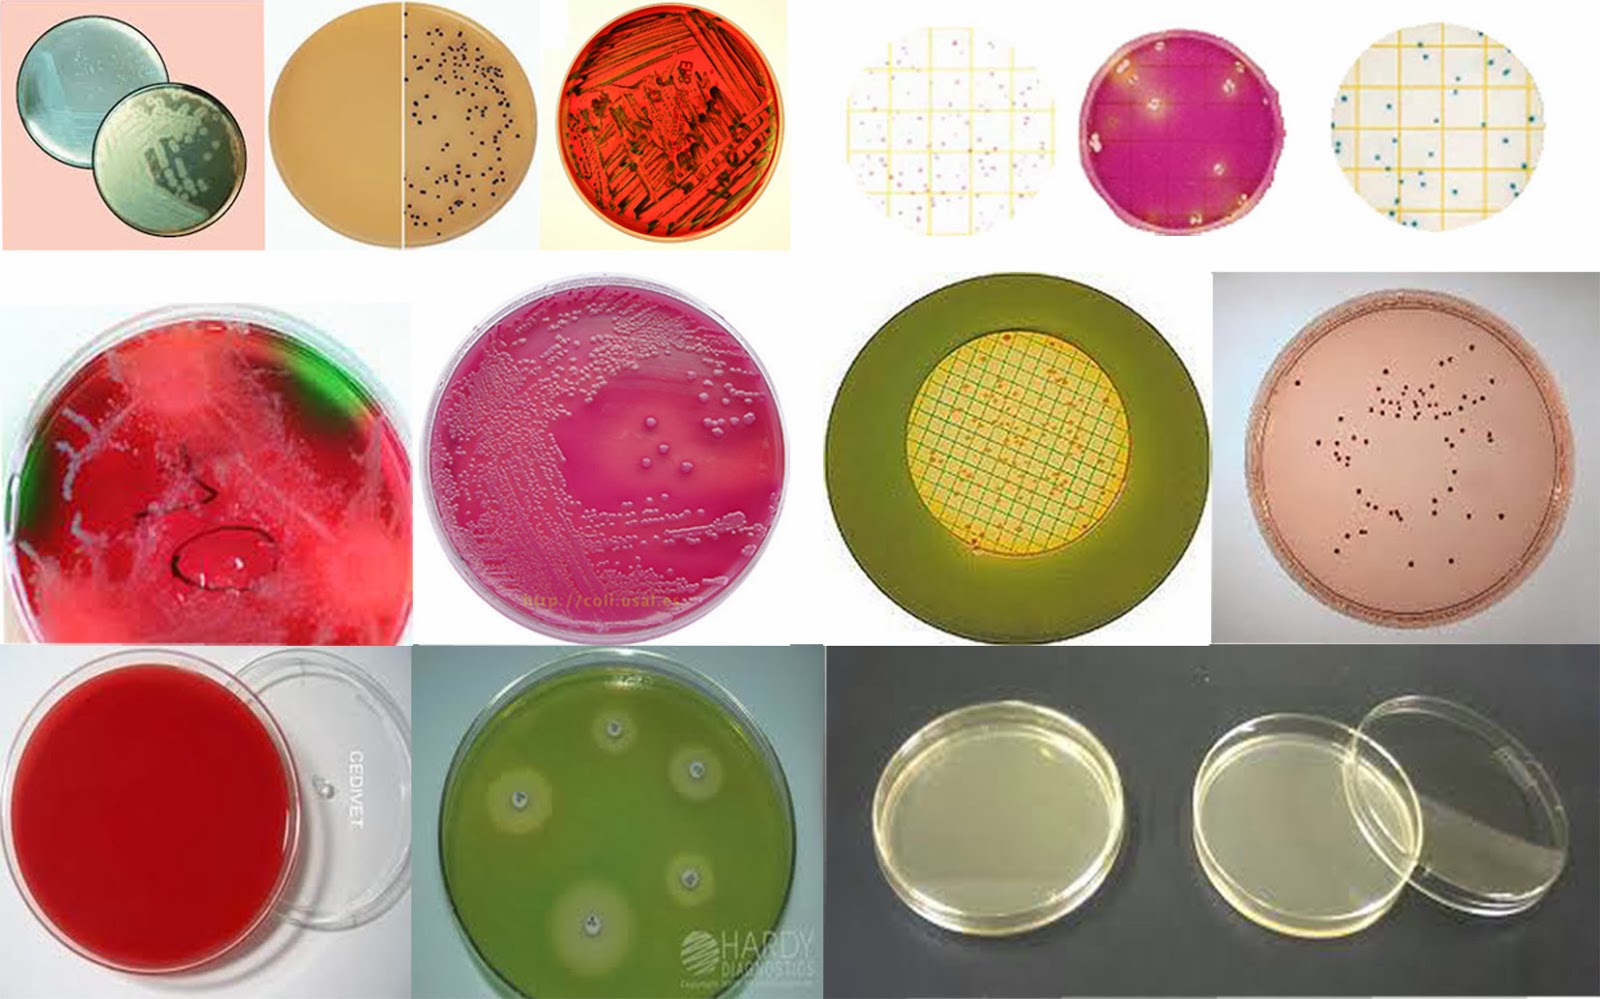
LABORATORIO Y MICROBIOLOGÍA MEDIOS DE CULTIVO

4.3: Cultivos en medios líquidos. Page ID. María M. Reynoso, Carina E. Magnoli, Germán G. Barros y Mirta S. Demo. Universidad Nacional de Río Cuarto. Índice. Sin encabezados. Se lleva el material con ansa en anillo o pipeta a un recipiente (frasco Erlenmeyer o tubo) conteniendo el medio de cultivo líquido. Generalmente este tipo de.. Figura 4.2.4 4.2. 4: (CC-BY; Este libero) Esta técnica permite sembrar inóculos sobre superficies grandes, para obtener un crecimiento confluente que nos permite estudiar el efecto de antimicrobianos (antibióticos, antisépticos, desinfectantes, etc.). También se utiliza para realizar recuento de colonias; para cumplir con este último.
.jpg)
¿Cómo se realiza un medio de cultivo?

Medios de cultivo, paso clave en la identificación de Behner SAS

Medios de cultivo la solución para el crecimiento microbiano Quo.mx

Medios de cultivo en microbiología Muy Fitness

Medio de cultivo 2 Apuntes 4 Medio de cultivo Aísla Categorí a Interpretación y reacciones

Medios De Cultivo

Medios de Cultivo en el Laboratorio de Microbiología YouTube

Medios de Cultivo JAS IMPORTACIONES SAC

Tabla comparativa de medios de cultivo Medios de Cultivo Tabla 1 Medio de cultivo Agar
LABORATORIO Y MICROBIOLOGÍA MEDIOS DE CULTIVO UTILIZADOS.

¿Cómo se realiza un medio de cultivo?

Medios de cultivo

AGAR MACCONKEY MEDIO DE CULTIVO SLIDO Lleva cristal

Preparación medios de cultivo Microbiología l Como preparar Medios de cultivo líquidos CALDOS

Tarea 3 Medios DE Cultivo Y SUS USOS UNIVERSIDAD DE GUAYAQUIL FACULTAD DE CIENCIAS MÉDICAS

Medios de cultivo

Medios DE Cultivo Nota 10 MEDIOS DE CULTIVO 1. Agar nutritivo El agar nutritivo es un medio

Medios de cultivo

¿CUALES SON LOS COMPONENTES PARA EL MEDIO DE CULTIVO? YouTube

Medios De Cultivo
Este medio es altamente selectivo para el aislamiento y diferenciación de especies del género Staphylococcus que son patógenas y pone de manifiesto la habilidad de S. aureus de fermentar el manitol.Es selectivo debido a la concentración de ClNa (7,5%, aproximadamente 10 veces más que un medio común), esta concentración elevada de sal inhibe la mayoría de los microorganismos que no.. Los medios de cultivo pueden ser creados específicamente para detectar la presencia de microorganismos patógenos que se encuentran en diferentes muestras, como alimentos, agua y muestras clínicas. Esto es de gran relevancia para la prevención y el control de enfermedades infecciosas. Enfermedades ocasionadas por microorganismos.




